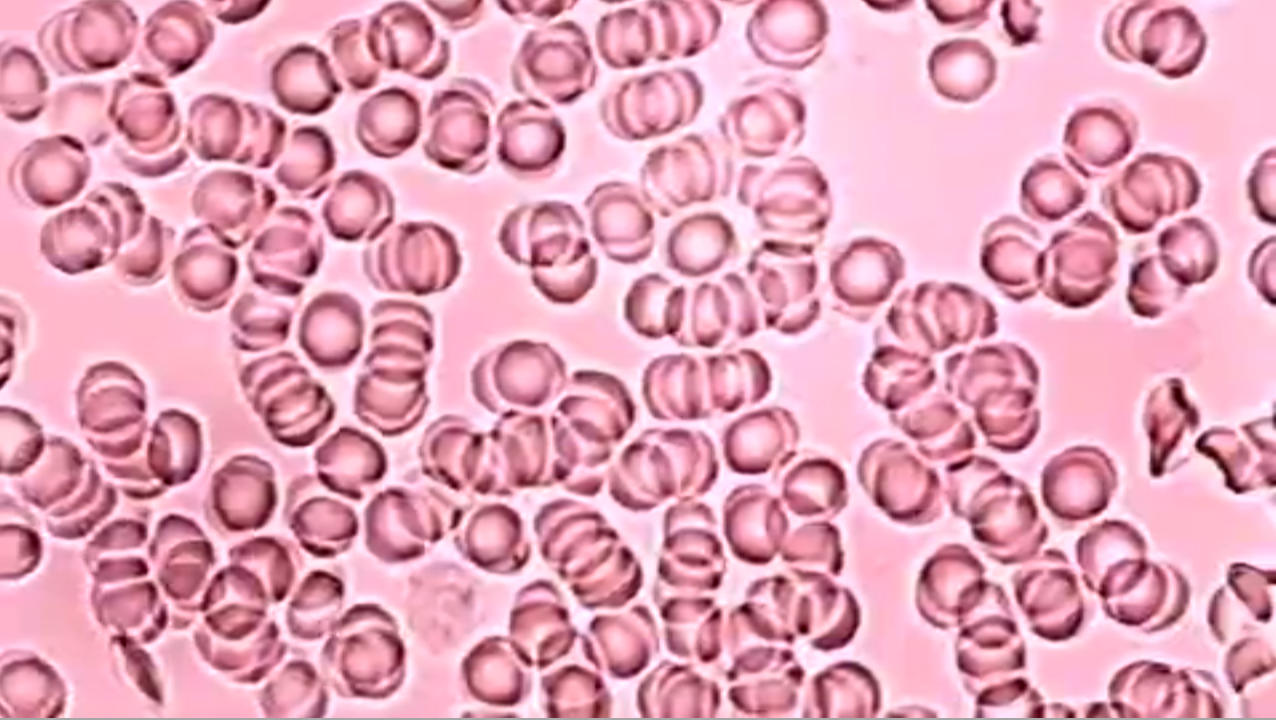

My work focuses on formulating an embodied, yet not humanistic, understanding of art specta(c)torship from a perspective grounded in a critical reading of the theory of individuation.
Affiliation: Independent
Since 2024 I am a member of Substantial Motion Research Network
Current Research Interests: Art and Technology, Philosophy of Individuation (Simondon, Deleuze, Stiegler, Hui), Net Art, Specta(c)torship
Unpublished writing
Experimental essay on AI Data Work (2025): Every Shift is A Work of Art: Infrathin Imaginary Artworks in Audio Transcription for AI Projects
Experimental book (draft): Specta(c)torship in Net Art(?): Individuation After Simondon
Published writing:
* for ethical reasons, I am committed to publishing exclusively open-access
In peer reviewed journals
Băcăran, Mihai. “On Being a Robot: Aisthesis and Sense in Audio Transcription for AI Projects” in Journal of Science and Technology of the Arts, Vol. 17, No.2, 2025, pp. 77-93. Open access at: https://revistas.ucp.pt/index.php/jsta/article/view/17898
Băcăran, Mihai. “Reading and Living the (Im)Material Movement of Sense: Jonathan Basile’s The Library of Babel and Xin Liu’s A Book of Mine” in Ex-Position Journal, Issue 52, 2024. Open access at: https://ex-position.org/wp-content/uploads/2025/01/05.-Mihai-Băcăran.pdf
Băcăran, Mihai. “The Mark of the Brief Night: Imminent Loss and Responsibility” in Transformations: Journal of Media, Culture & Technology, Issue 37, 2024. Open access at: http://www.transformationsjournal.org/wp-content/uploads/2024/10/Trans37_01_Bacaran.pdf
dalpofzs (Băcăran, Mihai, Darie Nemeș-Bota, Bogdan Dumitrescu, Alexandra Dumitrescu). “Dynamics of Sensemaking” in TECMERIN, Issue 13, No. 1, 2024. Open access at: https://tecmerin.uc3m.es/project/dynamics-of-sensemaking-2/?lang=en
Băcăran, Mihai. “(Dis)Orientation in Net Art: Disrupting the Feedback Loop of Cybernetic Subjectivities” in NECSUS_European Journal of Media Studies, Vol. 12, No. 2, 2023. Open access at: https://necsus-ejms.org/disorientation-in-net-art-disrupting-the-feedback-loop-of-cybernetic-subjectivities/
Băcăran, Mihai. “The Problematic of Embodiment in Online Specta(c)torship” in In Medias Res: International Scientific Journal for the Philosophy of Media, Vol. 12, No. 22, 2023, pp. 3609-3625. Download PDF
Băcăran, Mihai. “Revisiting 'Genesis': living as misspelling” in Revista humanidades, Vol. 13, No. 1, 2023. Open access at: https://revistas.ucr.ac.cr/index.php/humanidades/article/view/52598
Băcăran, Mihai. “Imaginary gestures of specta(c)torship: Darie Nemeș Bota’s 'Urban Seashell'” in Revista Muzica, Vol.XXXIII, No.2, 2022, pp. 38-55. Invited reprint of an earlier article, with further edits. Open access at: Download PDF here
Băcăran, Mihai. “Imaginary gestures of specta(c)torship: Darie Nemeș Bota’s 'Urban Seashell'” in Trivium. A multidisciplinary journal of humanities of Chandernagore College, Vol. 5, Issue 1, 2021, pp. 24-39. Open access at: https://trivium-journal.in/article.php?article=e9236cebe0b8130defbd1969d75a17b5
Băcăran, Mihai. “The Han Dynasty Tombs at Mawangdui. Image Analysis” in Buletinul Cercurilor Ştiinţifice Studenţeşti, No. 19, 2013, pp. 35-49. (in Romanian) Open access at: Download PDF here
Conference proceedings
Băcăran, Mihai. “Rethinking Embodiment at the Intersection of Art and Technology: The Argument For a Misosophy of Phenomenogenesis” in conference proceedings e-book Taboo-Transgression-Transcendence in Art and Science 2023, edited by Dalila Honorato, Margerita Pulè, Andreas Giannakoulopoulos, Clive Zammit, Adnan Hadziselimovic and Gabriel Zammit. Ionian University Publications, 2025, pp. 325-337. The e-book can be downloaded open access at: https://avarts.ionio.gr/ttt/2023/en/proceedings/
Băcăran, Mihai. “Snowflakes: The Individuation of Melting Memories” in conference proceedings e-book Taboo-Transgression-Transcendence in Art and Science 2020, edited by Dalila Honorato, María Antonia Gonzáles Valerio, Ingeborg Reichle and Andreas Giannakoulopoulos. Ionian University Publications, 2022, pp. 323-332. The e-book can be downloaded open access at: https://avarts.ionio.gr/ttt/2020/en/proceedings/
Other publications
Băcăran, Mihai. “Data Leaks” (video essay) in Digital America, Issue 26, Apr 2026. Open access at: https://www.digitalamerica.org/data-leaks-mihai-bacaran/. Includes an interview that can be accessed at: https://www.digitalamerica.org/mihai-bacaran-qa/?aiEnableCheckShortcode=true
Băcăran, Mihai. “It Is As If You Were Doing Work — A (Mis)Reading” in Hz Journal, No.21, 2019. Open access at: http://hz-journal.org/n21/bacaran.html
Băcăran, Mihai. “'Well, well! What an unenviable job judging must be!' — dissenting reports from the 1947 Travelling Scholarship and Art School Prizes”, article on the blog of University of Melbourne Archives, 8 October 2018. Open access at: https://blogs.unimelb.edu.au/librarycollections/2018/10/08/well-well-what-an-unenviable-job-judging-must-be-dissenting-reports-from-the-1947-travelling-scholarship-and-art-school-prizes/
Băcăran, Mihai. “Alternatives” in Arhitext, No.4, 2013. Download the PDF here
Conference presentations and other talks
“Traces: Notes on the Limits of Representation”, at Substantial Motion Research Network, March 2026
“An Argument for the Opaque: Specta(c)torship and AI Data Work”, at Beyond the Audience: Rethinking Participation and Power in the Age of Data Capitalism, IULM University, Rome, January 2026.
“Every Shift is a Work of Art: Notes On Audio Transcription for AI Projects”, at Taboo Transgression Transcendence in Art and Science, Kino Šiška, Ljubljana, September 2025.
“Imaginary Artworks and AI Data Work”, at Substantial Motion Research Network, April 2025
“Rethinking embodiment at the intersection of art and technology: the argument for a misosophy of phenomenogenesis”, at Taboo Transgression Transcendence in Art and Science, Malta Society of Arts, Valletta, 2023.
“Rethinking the Archive: 'Networks of Care' in Net Art” at the European Network for Cinema and Media Studies Conference, National University for Theatre and Film 'I.L. Caragiale', Bucharest, June 2022.
“Differenciations: reading and living the (im)material movement of sense” at English and American Literature Association of Taiwan Conference, online, 2021.
“'Networks of Care': Archival Practices in Net Art” part of the panel “Anarchival Tendencies: Performance in/as/of archives” chaired by Prof. Rachel Fensham, English and Theatre Studies Seminar Series, University of Melbourne, online, October 2021.
“Snowflakes. The Individuation of Melting Memories” at Taboo Transgression Transcendence in Art and Science, University of Applied Arts, Vienna/online, 2020.
“The Question of Spectatorship: a Critical Reading of Gilbert Simondon” at AAANZ Conference, University of Auckland, 2019.
“Intelligent Bodies: Who Wrote this Paper?” at Bodies of Work, Postgraduate Conference, University of Sydney, 2019.
“The case for a human body” at Quite Frankly: It’s a Monster Conference, SymbioticA, University Of Western Australia, 2018.
“The Han Dynasty Tombs at Mawangdui. Image Analysis” at The National Session for students and PhD students – Archaeology – History – Museology, 20th edition, the University 1 December Alba Iulia , Alba Iulia, 2012.
I have created the independent, open access, online course Net Art: A Problematic Introduction in collaboration with artist and musician Darie Nemeș Bota. Available open access at: https://spectactor.thinkific.com/courses/net-art
Since 2013 I am active in the contemporary art collective dalpofzs: www.dalpofzs.com
Solo works:
Searching for Gradiva's Step (2025) - video work + text

Searching for Gradiva's Step was screened in the official competition at the Punto y Raya Festival 2025: https://www.puntoyrayafestival.com/fest/editions
Data Leaks (2025) - video work + text
Data Leaks is part of Every Shift is A Work of Art: Infrathin Imaginary Artworks in Audio Transcription for AI Projects
Data Leaks was included in Issue 26 of Digital America, Apr 2026: https://www.digitalamerica.org/data-leaks-mihai-bacaran/
How to Say in Russian "Hey, Kevin, You'Re a Dick!"? (2025-2026) - an imaginary piece of electronic literature

Folding Artificial Words (2026) - video work + text

Folding Artificial Words is an audio-video essay that engages with Artificial Intelligence from an oblique critical perspective. It uses creative coding, the audio recording of a private performance, generative sound, and microscopic footage to interrogate the interrelation between the natural and the artificial in the understanding of AI technologies.
Education:
PhD in Art Theory, The University of Melbourne, 2018-2022
Dissertation: Specta(c)torship in Net Art(?): Individuation After Simondon
MA in Art Theory, Beijing Normal University, 2014-2017
Chinese language program, Henan University, International School for Chinese Language and Culture, 2013-2014
BA in Art History, University of Bucharest, 2010-2013
BFA Acting, National University for Theatre and Cinematography ‘I. L. Caragiale’ Bucharest, 2007-2010
Contact: bacaran.mihai[at]gmail.com